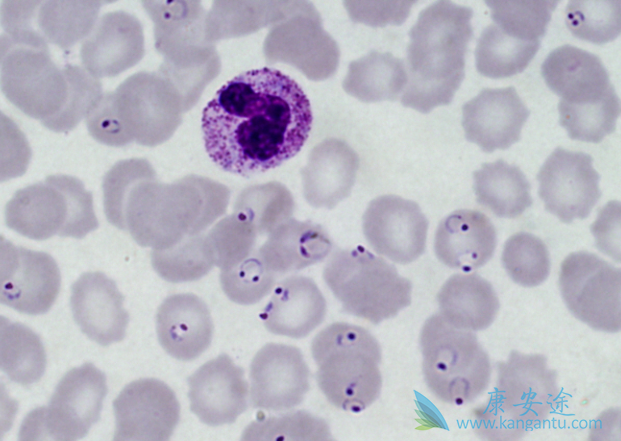
űԭ

过年期间一条新闻“震惊”了朋友圈——起因是中国科学院官方微博发布了一条消息:“疟原虫与癌细胞,看似并没有什么联系,却意外被科学家发现,它能“以毒攻毒“杀死癌症…”随后,大量的自媒体开始转载,并且声称中国科学家找到办法“成功治愈晚期癌症”、“癌症被攻克”,“虽然目前还没有100%的把握,但这个用疟疾治愈晚期癌症的实验已经成功,并且用于临床治疗”。
那现实是否就像武侠作品中“五毒教”一样用毒蛇、蜈蚣、蝎子、蜘蛛和蟾蜍就能治疗呢?疟疾这个曾经让人类死亡率高企的"大反派"是否化身为最大的“正角儿”,成了对战癌症的“特效药”?其实,真相远没有那么简单,距离疟原虫治疗癌症应用到普通治疗还有很长很长的路要走,还有很多研究要做!
疟原虫具体是通过怎样的机理激活人体免疫系统起到治疗癌症作用?还不清楚!怎么才能控制疟原虫感染之后不造成严重的不良反应?还没有!是否能够用更安全同时又能与疟原虫一样激活免疫细胞的其他物质代替疟原虫?还没研究!疟原虫感染治疗癌症的临床效果怎样,临床数据是多少,有效率是多少?还没有具体数据!这些问题都还没有答案!这些问题都还没有答案何谈“癌症被攻克”。
现在很多自媒体宣传的疟原虫“成功治愈晚期癌症”、“癌症被攻克””、“只需一针一毫升疟原虫的血”是个严重的错误描述,严重的误导了老百姓。“疟原虫治愈癌症”只是在研究阶段,并且处在早期研究阶段,治疗效果及存在的治疗副作用都完全没有确定。此外,疟原虫本身的传染以及致病性,治疗过程存在很大风险。
更多新闻请您访问 肿瘤 https://www.kangantu.com/














请简单描述您的疾病情况,我们会有专业的医学博士免费为您解答问题(24小时内进行电话回访)